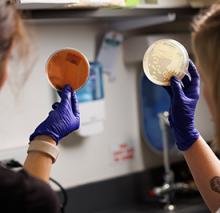
duke pediatric research scholars program

Education and Training
The Duke University School of Medicine Department of Pediatrics provides a wide range of educational opportunities for those dedicated to improving children’s health care and advancing pediatric research.
Our comprehensive training programs are designed for today’s trainees. The renowned faculty in Duke Pediatrics foster a supportive and collaborative environment, allowing trainees to explore their research interests while gaining the skills and knowledge necessary to become the pediatric leaders of tomorrow.
Why Choose Duke
There are many reasons to choose Duke. See for yourself.